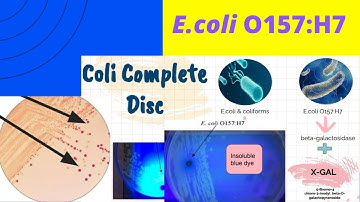
E.coli O157:H7 A Foodborne pathogen-Enrichment & Isolation|EEB,SMAC, TSYE,EMB and Coli complete Disc

⬇ DOWNLOAD NOW
Kalau muncul iklan pop-up, tutup lalu klik tombol kembali
Download lagu Detection: Live E Coli O157:H7 Cells By PMA-qPCR l Protocol Preview secara gratis hanya untuk keperluan promosi. Dukung artis favorit kamu dengan membeli musik original di iTunes atau platform resmi lainnya.
 Foodborne Pathogen Screening: Rapid Detection Of E. Coli O157:H7-Preview
Foodborne Pathogen Screening: Rapid Detection Of E. Coli O157:H7-Preview
 E coli O157 H7 Infection
E coli O157 H7 Infection
E.coli O157:H7 A Foodborne pathogen-Enrichment & Isolation|EEB,SMAC, TSYE,EMB and Coli complete Disc
E.coli O157:H7 A Foodborne pathogen-Enrichment & Isolation|EEB,SMAC, TSYE,EMB and Coli complete Disc
 Controlling E. coli O157.H7: Study Verifies Efficacy of Vaccine for Deadly Pathogen
Controlling E. coli O157.H7: Study Verifies Efficacy of Vaccine for Deadly Pathogen
 PMA-qPCR
PMA-qPCR
 PMA & PMAxx™: The Industry Leader in Microbial Viability Detection(Viability PCR)
PMA & PMAxx™: The Industry Leader in Microbial Viability Detection(Viability PCR)
 E. Coli O157: H7
E. Coli O157: H7
 E.Coli O157:H7
E.Coli O157:H7